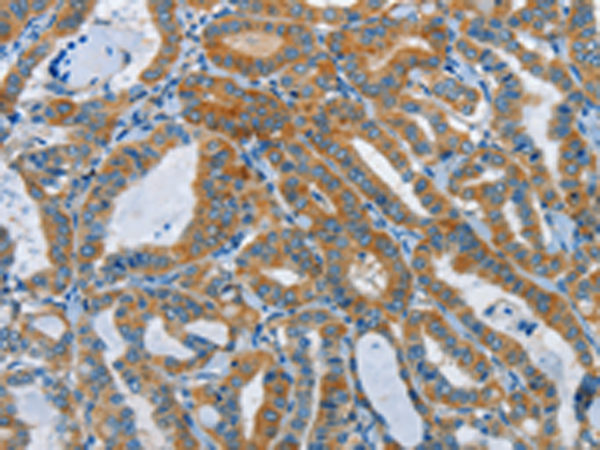
一抗

|
Background: |
This gene belongs to the dimethylarginine dimethylaminohydrolase (DDAH) gene family. The encoded enzyme plays a role in nitric oxide generation by regulating cellular concentrations of methylarginines, which in turn inhibit nitric oxide synthase activity. Impairment of DDAH causes ADMA accumulation and a reduction in cGMP generation. DDAH II, the predominant DDAH isoform in endothelial cells, facilitates the induction of nitric oxide synthesis by all-trans-Retinoic acid (atRA). DDAH proteins are highly expressed in colon, kidney, stomach and liver tissues. |
|
Applications: |
ELISA, IHC |
|
Name of antibody: |
DDAH1 |
|
Immunogen: |
Synthetic peptide of human DDAH1 |
|
Full name: |
dimethylarginine dimethylaminohydrolase 1 |
|
Synonyms: |
DDAH |
|
SwissProt: |
O94760 |
|
ELISA Recommended dilution: |
1000-5000 |
|
IHC positive control: |
Human thyroid cancer and Human brain |
|
IHC Recommend dilution: |
50-200 |

 購物車
購物車 幫助
幫助
 021-54845833/15800441009
021-54845833/15800441009